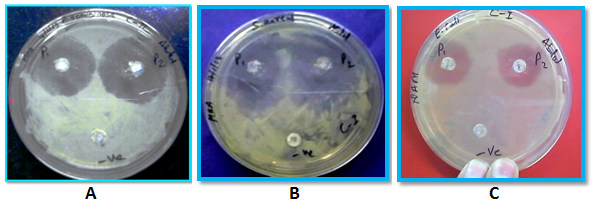
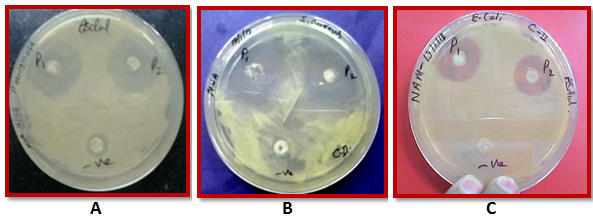

Applied Mechanics Department, Motilal Nehru National Institute of Technology, Allahabad, UP, 211004, India.
Email: sjpawar@mnnit.ac.in
Received: 15 Jun 2014 Revised and Accepted: 01 Aug 2014
ABSTRACT
Objective: The main aim of the current study is to show an anti-infective coating on biomedical implants, one of the novel approaches to control the biofilm formation.
Methods: In this study, the coating was employed by the slurry of Polyvinyl alcohol (PVA), Polyethylene glycol (PEG) and Chitosan with encapsulated Gentamicin Sulphate (GS) using Slurry-dipping technique on Silicon. Two different strategies were followed to coat the Silicone namely Coating I with chitosan and Coating II without chitosan. Drug encapsulation efficiencies of Coating I and Coating II were found to be 86.8% and 83.96% respectively.
Results: In vitro drug release profile of Coating I and Coating II in phosphate buffer saline at pH 7.4 for 48 hrs were found to be 30.3µg/ml and 24.2 µg/ml respectively. Antimicrobial activity of coated samples against Staphylococcus aureus, Pseudomonas aeruginosa and Escherichia coli showed effective results. Biofilm formation was investigated by XTT reduction assay which showed reduction of biofilm on coated sample with respect to the uncoated sample. Biocompatibility of coated sample was confirmed by MTT assay against SW-71 trophoblast cell-lines and hemolysis test against fresh human blood. Surface morphological analysis using SEM confirmed the uniform coating and AFM showed the average surface roughness reduction in coated sample.
Conclusion: The present study indicated that GS encapsulated PVA, PEG and Chitosan cross linked polymer coated Silicone can be potentially used for production of Silicone based implant.
Keywords: Biofilm, Biomedical implant, Silicone, Biocompatibility, Cytotoxicity, Drug encapsulation, Hemocompatibility.
INTRODUCTION
A biofilm is an aggregate of the microorganism that is irreversibly associated with a surface and embedded in a self produced matrix of primarily polysaccharide material. Biofilm may form on a wide variety of surfaces, including biomedical implants [1]. A medical implant is a device which is either partly or totally introduced, surgically or medically, into a human body to support damaged biological structure, or to enhance an existing biological structure[2]. Majority of these implants, residing within tissues are infection free; a small percentage, however, become infected. These infections are due to the formation of a biofilm on the surface of the implant. Eventually, if the microbes succeed in forming a biofilm within the human host, the infection often turns out to be untreatable and will develop into a chronic state. The chronic biofilm-based infection shows resistance to antibiotics and many other conventional antimicrobial agents. They also exhibit an utmost capacity for evading host defence system since the biofilm which harbour microbes is enclosed in a complex extracellular matrix. This matrix serves as a barrier to immune surveillance and limits the efficacy of systemic and local antibiotics [3]. Following the biofilm development, microbial cells from the biofilm proliferate and disperse into the bloodstream causing fatal infection to the corresponding organ(s) [4]. These microbes are easily accessible during surgery and adhere to the implant surface. They are also guided by the patient's own proteins to from a biofilm on an implant and make the treatment of implant related infections more challenging [5]. Thus, the biofilm related infections lead to high morbidity and mortality for patients and increases the cost of healthcare.
The biofilm microbes which are less susceptible to antibiotics treatment and host defence system are mostly the bacteria and fungi [6]. The bacteria that causes device related infections are common skin flora (e. g., Staphylococcus epidermidis and Staphylococcus aureus) and common environmental organisms (e. g., Pseudomonas aeruginosa); alongside, certain fungi species (e. g., Candida albicans and Aspergillus fumigatus) predominates in infections of certain devices. The staphylococci species including S. aureus and S. epidermidis are responsible for the majority of biofilm formation on implanted orthopaedic devices [7] and on synthetic vascular grafts prostheses[8]. Pseudomonas aeruginosa is another less frequently found gram-negative species which have also been identified in implant infections[9]. The therapeutic interventions which are under development to prevent and treat biofilm caused infections in medical implant include small molecules and matrix-targeting enzymes, bactericidal and anti-adhesion coatings. On one side, small molecules and enzymes have been investigated to inhibit or disrupt biofilm formation whereas, on the other side, the anti-biofilm coatings have been targeted to modify the surface of medical devices by preventing the enhanced bacterial adhesion leading to high resistance to the biofilm formation [10].
This research has developed a convenient method for preparing anti-infective coating on Silicone implant by using two type of combination of polymers viz. Polyvinyl alcohol (PVA) and Polyethylene Glycol (PEG) along with Chitosan with encapsulated Gentamicin sulphate (GS) to achieve better encapsulation efficiency and controlled drug release profile.
The antibacterial activity of coated Silicone pieces has been studied along with the estimation of biofilm formation on the test pieces using in vitro biofilm formation assay. The biocompatibility of coated implant have been determined using in vitro method like hemocompatibility and cytotoxicity for which the surface topography of the drug encapsulated polymers coated Silicone pieces have been observed using specific topographical analysis (SEM and AFM).
MATERIALS AND METHODS
Chemicals and reagents
In the present study, commercially available Silicone Foley Catheter (URO-FLEX, Kawa Medithech Enterprise Inc., Japan) was used as a test material. Silicone catheter (6 mm diameter) was cut into 1 cm pieces with average weight of 280 mg. For coating on Silicon, PEG (Sigma Aldrich, India), PVA (Sigma Aldrich, India), Chitosan (S. D. Fine Chemical Ltd., Mumbai) and Gentamicin Sulphate (Hi Media, India) were used.
Coating of Silicone Test Material
Silicone pieces were coated with two different combination of PEG, PVA with and without Chitosan as polymer encapsulated with GS. Coating with GS encapsulated PEG + PVA + Chitosan polymer on Silicone piece was named as Coating I and the coating with GS encapsulated PEG+PVA polymer was named as Coating II. For coating of test pieces, slurry dipping technique was adapted [11]. The coating process started with preparation of stable slurry with specific amount of GS. Appropriate slurry temperature of coating was determined by trial-and-error approach to achieve optimum coating thickness, uniformity and stability of coating as well as an adequate encapsulation of drug particles into coating Structure[12].
Drug release profile and drug encapsulation efficiency analysis
Generally, GS poorly absorbs ultraviolet and visible light so an indirect spectrophotometric method was followed. Ninhydrin colorimetric reaction is commonly used method for the qualitative identification of several drugs containing amino groups [13]. Frutos et al [14] in 1999 reported a quantitative colorimetric assay for GS based on Ninhydrin colorimetric reaction with primary and secondary amines present in the GS. This reaction produces a purple colour which indicates that the maximum absorption take place at 400 nm. Ninhydrin Colorimetric Assay was used to evaluate the in vitro drug release test as well as encapsulation efficiency of GS in GS encapsulated PEG/PVA/Chitosan cross linked polymer coated Silicone. The release of GS from coated Silicone was assayed in duplicate under sink condition. Each sample was incubated in phosphate buffer saline (PBS) (pH 7.4) at 37°C for 5 minutes in shaker. After 1, 2, 4, 7, 10, 14, 21, 25, 33, 38, and 48 hrs, 1 ml of aliquot was withdrawn and subjected to Ninhydrin Colorimetric Assay [14]. To calculate the encapsulation efficiency in coating, the free drug was separated from encapsulated drug. The test samples of both type were suspended in PBS and the cross linked PEG/PVA/Chitosan polymers were solubilised by Dimethyl Sulfoxide (DMSO) and kept for overnight at 37°C and the released drug was subjected to the Ninhydrin Colorimetric Assay. Encapsulation efficiency was calculated based on the ratio of actual GS concentration to theoretical loading, expressed as percentage.
Entrapment efficiency (%) = [(total amount of drug - amount of free drug) / total drug] x100(1)
Antimicrobial testing
Antimicrobial properties of the coated Silicone were evaluated through agar diffusion method against three strains of bacteria namely Staphylococcus aureus, Pseudomonas aeruginosa and Escherichia coli. Coated Silicone pieces were placed in duplicate along with uncoated Silicone piece as negative control on three bacterial streaked plates. These plates were incubated at 37°C for overnight. The appearance of zone of inhibition was observed next day which was measured using a HiAntibiotic ZoneScaleTM-C (Hi Media, India) and photographs of zone of inhibition were taken for analysis.
Biofilm formation assay
For the investigation of biofilm formation against S. aureus, P. aeruginosa and E. coli, on drug encapsulated polymer-coated Silicone, (2, 3-bis [2-Methoxy-4-nitro-5-sulphophenyl]-2H-tetrazolium- 5-carboxanilide) (XTT) reduction assay was performed by semi-quantitative measurement. The XTT reduction assay involves metabolic reduction of XTT to a water soluble brown formazan product. It determined the mitochondrial dehydrogenase activity, an indicator of the metabolic state of the microbial cells [15, 16]. Biofilm on coated Silicone and uncoated Silicone was made by incubating test pieces in 18 hrs incubated test culture. Then the samples were incubated for 24 hrs at 37°C in Biological Oxygen Demand (BOD) Incubator (biofilm growth phase). After 24 hrs, test pieces were kept into 24 well cell culture plates (CELLSTAR) and XTT-menadione reagent [17] was added to each test well and incubated in the dark for 3 hrs at 37°C. Color changes in the solutions were measured spectrophotometrically at 490 nm. All these tests were done in duplicate.
Hemocompatibility assay
Hemolysis is the rupturing of red blood cells (RBC’s) and the release of their contents into surrounding fluid. Total hemolysis test was assessed as described according to Practice F756 – 08[18] with human erythrocytes. Test for hemolysis was performed with an isotonic extract of the test material, as described in practice F619 – 03[19] in contact with the human blood. The specimens (1 cm length) of Coating I and Coating II were incubated in normal saline for 24 hrs at 37°C in BOD incubator. After incubation, the resultant test liquids (extract liquids) were taken as test with 0.1 % Sodium Carbonate as positive control and 0.9 % NaCl (Normal Saline of pH 7.2-7.4) as negative Control. For hemolysis test, fresh 200 µl diluted blood was mixed in each extract, positive and negative sample. These samples were incubated for 3 hrs at 37 ºC and centrifuged to remove any solid particles. Samples were read at 540 nm on enzyme-linked immunosorbent assay (ELISA) reader and the % hemolysis has been calculated based on these results as per following formula.
% hemolysis = [OD test – OD of NC] / [OD of PC - OD of NC] ×100(2)
Where, NC and PC stand for negative control and positive control, respectively.
Cytotoxicity analysis
The toxicity can be measured by assessing cellular damage in culture media. Cytotoxicity was evaluated using MTT 3-(4, 5-dimethylthiazol-2-yl)-2, 5-diphenyltetrazolium bromide survival assay[15]. The extract sample for cytotoxicity test was prepared according to ASTM standard F619 – 03. The three different test materials Coating I, Coating II and uncoated Silicone were added separately in 10 ml Dulbecco’s modified essential media (DMEM) for 24 hrs at 37°C. After the incubation, the prepared media alone was used as extract. The SW71 cells were seeded (3000 cells/well) in 96 well microtitre plates in triplicate, supplemented with 10% DMEM. Then, 100 µl extract sample was added in media in triplicates along with fresh media alone for control. Finally, these were incubated for 24 hrs at 37°C. After incubation, MTT (5 mg/ml) was added to each well and the formazan crystals were dissolved by DMSO. The absorbance was recorded on a microtitre plate reader at the wavelength of 540 nm and referenced at 630 nm. The percentage cytotoxicity was calculated by the formula:
Cytotoxicity = [(O. D of control – O. D of test) / O. D of control] × 100 (3)
Scanning electron microscopy (SEM)
The surface morphological study was carried out using a SEM (LEO Electron Microscopy Ltd., England). A thin layer of platinum was coated to make the samples conductive by using sputter coater unit (VG Microtech, England). LEO-430 SEM machine was operated at a vacuum of order 10-5 torr and the accelerating voltage of the microscope was kept in the range 15-20 kV.
Atomic force microscopy (AFM)
The surface topology of the films was also investigated by AFM. It is a very high-resolution type of scanning probe microscopy which demonstrated resolution on the order of fractions of a nanometer. Dimension 3000 scanning probe microscope with tapping mode AFM was used to analyze roughness of biomaterial samples (5x5 µm). The average roughness was then calculated by Nanotec Electronica WSxM software[20] and represented as the arithmetic average of the deviation from the center plane. Three points were analyzed on each square and results were expressed as mean ± standard deviation.
Statistical analysis
Statistical evaluation for correlation of GS versus absorbance was performed using linear regression model. The repeated measure analysis was used to compare mean concentration of GS release from polymer coated Silicone pieces at different time. Meanwhile, the comparison of cumulative release of GS from Coating I and Coating II for 48 hrs was evaluated using independent sample test. Statistical evaluation was performed using Microsoft Office Excel (Microsoft Office Excel for Windows; 2007). All results were expressed with mean (standard error of mean). P ≤ 0.05 was considered to be a significant value.
RESULTS AND DISCUSSION
Drug release profile and drug encapsulation efficiency
Ninhydrin Colorimetric Assay is a powerful technique for detection of GS even if it is present in trace amount. Amines present in the GS react with Ninhydrine to make Gentamicin-ninhydrine complex which gives purple colour and shows maximum absorption at 400 nm wave length. For drug release profile and drug encapsulation efficiency determination, first a calibration curve with known concentration of GS versus absorbance at 400 nm is drawn, so that a suitable relationship between concentration of GS and absorbance can be obtained. The standard curve of absorbance of GS was plotted in the range of 10 to 130 μg/ml and coefficient of determination (R2) and equation for line was obtained. The calibration curve is presented in figure 1. The curve indicated that R2 is 0.9782 which clearly illustrates the linear relation between absorption and concentration of GS.

Fig. 1: Calibration curve between absorbance versus concentration of GS.
Drug release profile study was performed with the help of Ninhydrin Colorimetric Assay. Drug encapsulated polymers coated Silicone pieces were placed in a tube containing 40 ml of PBS (pH 7.4) and kept at 37 °C. All the samples were placed on a shaker and after each designated time interval, 1 ml of PBS sample aliquot was withdrawn and the same volume of PBS was then replenished. All samples were subjected to Ninhydrin Assay and absorbance of GS at 400 nm was taken. The amount of drug released at different time intervals was calculated with the help of calibration curve (Figure 1). Figure 2 shows the drug release after the designated time intervals up to 48 hrs.

Fig. 2: Concentration of GS release from Coating I and Coating II in PBS solution over each sampling interval for the 48 hrs study period (P=0.004).
The in vitro drug release profile in 40 ml phosphate buffer saline of pH 7.4 up to 48 hrs show 30.3 µg/ml and 24.2 µg/ml (P=0.004) drug release from Coating I and Coating II, respectively. It is observed that the initial release of GS up to 1 hr is as high as 11.5 µg/ml and 16.5 µg/ml from Coating I and Coating II, respectively.Then after, there is a sudden change (decrease) in the trend of concentration of GS release. Additionally, it is also exhibited that there is again a small change (increase) in the trend of concentration of GS release. Significant different in the concentration of GS release is observed for Coating I and Coating II.
The drug encapsulation efficiency of coated Silicone pieces was also determined with the help of Ninhydrin Colorimetric Assay. Encapsulation efficiency was calculated based on the ratio of actual GS concentration to theoretical loading, expressed as percentage. Coating I shows the higher encapsulation of drug I (EE; 86.8 %) than Coating II (EE; 83.96 %).
Antimicrobial testing
It is expected and found that the drug was successfully encapsulated in polymer which was coated on the Silicone pieces. To check the encapsulation of drug on coated Silicone, antimicrobial test was performed. Initially, the effectiveness of the released drug was studied, which involved the use of bacterial colony to check the formation of zone of inhibition. The antimicrobial test was done on a nutrient agar plate and Mueller Hinton Agar (MHA) against P. Aeruginosa, S. aureus, and E. coli strains. The main aim of this test was to see the zone of inhibition compared with uncoated Silicone piece. During this test, it was observed that the drug has been loaded during coating and when checked on agar plates, it is found that the drug diffuses with agar and gives zone of inhibition which is shown in figures 3a and 3b.
Fig. 3a: Zone of inhibition of Coating I against; (A) P. aeruginosa,(B) S. aureus and (C) E. coli
Fig. 3b: Zone of inhibition of Coating II against; (A) P. aeruginosa,(B) S. aureus and (C) E. coli.
The Comparative study of Antimicrobial activity of Coating I and Coating II tested against Pseudomonas aeruginosa, Staphyloccus aureus, and Escherichia coli on the basis of zone of inhibition is showed in figure 3c. Both type of coating have showed good antimicrobial activity, however Coating I shows higher antimicrobial activity then Coating II. Based on figures 3a and 3b, one can easily see the comparison of zone of inhibition of two Silicone pieces and negative Silicone piece in case of both coatings. Similarity zone of inhibition is also found with reference to particular strains, which is further evident from figure 3c also. Highest zone of inhibition is found for S. aureus which further reduces to P. aeruginosa and E. coli.
Biofilm formation assay
Biofilm formation assay was performed against E. coli, S. aureus and P. aeruginosa on coated and uncoated Silicone pieces with the help of XTT/Menadione reduction assay and investigated. The figure 4 shows absorbance and their deviation with uncoated Silicone, Coating I and Coating II with E. coli, S. aureus and P. aeruginosa. Biofilm formation assay shows the significant reduction of biofilm formation on coated Silicone pieces with reference to uncoated Silicone pieces.

Fig. 3c: Comparative study of Zone of inhibition of coating I and Coating II against P. aeruginosa, S. aureus and E. coil.

Fig. 4: Biofilm formation assay show the reduction of biofilm formation on coated Silicone pieces with respect to uncoated Silicone piece.
Heamocompatibility
The hemolytic activity of biomaterials plays an important role with regards to toxicity and correlates with inhibition of cell growth. From the absorbance at 540 nm, % hemolysis is calculated as given in Table 1.
Table 1: Haemolytic grade (ASTM; F756-08, 2009)
| Haemolytic Index above
the negative control |
Haemolytic Grade |
| 0–2 | Non haemolytic |
| 2–5 | slightly haemolytic |
| >5 | Haemolytic |
It is observed that the average % hemolysis of Coating I and uncoated Silicone piece is 1.3 % and 1.4 %, respectively which shows that this material falls in non hemolytic category as compared with hemolytic grade. But average % hemolysis of Coating II is 3.6 % which shows that it is slightly hemolytic. Overall, both types of coating is said to be hemocompatible which can be shown in figure 5.

Fig. 5: Comparative study of % Haemolysis of Coating I, Coating II and Uncoated Silicone piece.
Cytotoxicity
For the drug delivery and anti biofilm formation of medical implant, coating should exhibit minimal cytotoxicty. Cytotoxicity test based on MTT assay against SW-71 trophoblast cell line shows that the cells are viable up to 95.6 % in case of Coating I and 87.6 % in the case of Coating II, which has been compared with media control. Both types of coating show good biocompatibility for in vivo application. The comparative result of cytotoxicity is shown in figure 6. It is noticed that the maximum cytotoxicity is found in Coating II which is in the limit of tolerance that may be due to toxicity of DMSO, used in the preparation of slurry for coating. Maximum cells were viable in Coating I so that it has less cytotoxicity. Since the biological evaluation of coated implant material is found to be non toxic and do not exert any cytotoxic effect on SW-71 human trophoblast cell line, so both are considered as biocompatible.

Fig. 6: Cytotoxicity of coated and uncoated silicone pieces (P=0.0009)
Scanning electron microscopy (SEM)
From the SEM micrograph of the surface of drug encapsulated polymer coated Silicone pieces, it is found that the clear image of uniformly coated layer without any pores is observed in figures 7a and 7b. For reference, the microscopic studies of uncoated Silicon piece is also shown in figure 7c. The SEM study showed that the drug encapsulated polymer coated Silicone piece produced a rough surface rather than a smooth one as uncoated Silicone.

Fig. 7: SEM images of coated and uncoated Silicone piece. Image A: coating I, image B: coating II, and image C: uncoated Silicone piece.
Atomic force microscopy (AFM)
AFM gives three dimensional surfaces topographic image of GS encapsulated polymer coated Silicone pieces. AFM results of drugs coated as well as uncoated Silicone pieces are shown in figure 8a. The surface roughness of sample was calculated from AFM images. On the basis of surface roughness, bacterial adherence ability over Silicone has been analysed. In this study surface roughness of coated and uncoated Silicone pieces was calculated from the AFM images by nanoscope software; WSxM, for data acquisition and processing in Scanning Probe Microscopy [20]. The calculated average surface roughness of coated and uncoated Silicone pieces is shown in figure 8b which give a comparison of average surface roughness. AFM was also carried out for drug encapsulated polymers coated sample for surface topology in which the different positions of the sample were monitored. The surface pattern is shown in Figure 8a. Bacterial adherence on the surface of implant was also affected by surface roughness. Ideally, the surface should be smooth so that there will be less attachment or adherence of microorganisms. Surface roughness calculated from the AFM image show the reduction of surface roughness in comparison to the uncoated Silicone piece. Coating also helps in the improvement of surface topology which also contributes in biofilm inhibition.

Fig. 8a: Three dimensional surface Image of AFM at 5x5 µm surface area. A: Coating I, B: Coating II and C: Uncoated Silicone

Fig. 8b: Comparative representation of Average Surface Roughness of coated and uncoated silicone piece obtained from AFM.
CONCLUSIONS
In this research, an easily accessible coating method for biomedical implant with coating of drug encapsulated polymers has been successfully presented which has a potential to prevent biofilm formation. Successfully coated Silicone pieces with GS encapsulated PEG/PVA/Chitosan cross linked polymers (coating I) and GS encapsulated PEG/PVA cross linked polymers (Coating II) were subjected to various chemical, biological and topological characterization. The overall analysis of all physiochemical and biological parameters, lead to the conclusion that the Coating I shows the best result which have low drug releasing capacity, good drug encapsulation efficiency, good antimicrobial activity and a best ability to reduce biofilm formation.
This coating affects the microbial adhesion and GS being an antimicrobial agent exert metabolic interference in biofilm formation and inhibit the growth of E. coli, S. aureus and P. aeruginosa on biomaterial surface. This coating also modifies the surface roughness of the biomaterials which in turn affect the adhesion of E. coli, S. aureus and P. aeruginosa cells on its surface and prevent its biofilm formation.
The hemolysis and cytotoxicity test of Coating I show that it comes under good biocompatible biomaterial. Although the results of Coating II was not as good as the Coating I, but it also have good biomaterial properties and also have ability to reduce biofilm formation. Such coatings can effectively be used for preparation of biomedical implant with properties to prevent the biofilm formation.
Materials PVA and Chitosan which are used in combination as Coating I have shown slow rate of biodegradability as compared to that of Coating II and thus can resist the rate of degradation once implanted into body. Optimized material combination in coating I may be fabricated as scaffold and other drug delivery system for applicative measure in tissue engineering
CONFLICT OF INTERESTS
Declared None
REFERENCES